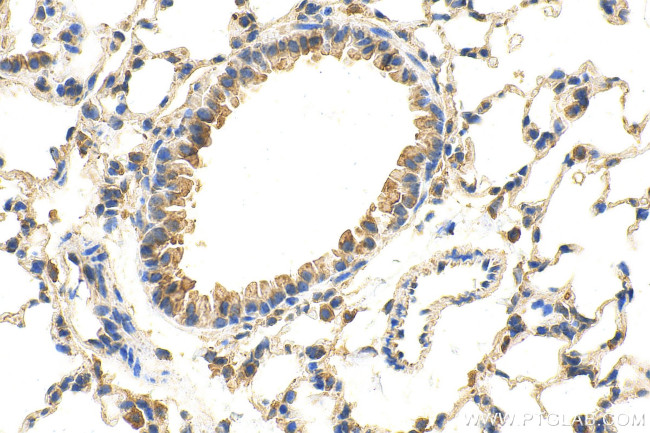
ADRB1 Antibody in Immunohistochemistry (Paraffin) (IHC (P))

Search
Proteintech
ADRB1 Polyclonal Antibody
{{$productOrderCtrl.translations['antibody.pdp.commerceCard.promotion.promotions']}}
{{$productOrderCtrl.translations['antibody.pdp.commerceCard.promotion.viewpromo']}}
{{$productOrderCtrl.translations['antibody.pdp.commerceCard.promotion.promocode']}}: {{promo.promoCode}} {{promo.promoTitle}} {{promo.promoDescription}}. {{$productOrderCtrl.translations['antibody.pdp.commerceCard.promotion.learnmore']}}
产品信息
28323-1-AP
种属反应
宿主/亚型
分类
类型
抗原
偶联物
形式
纯化类型
保存液
内含物
保存条件
运输条件
产品详细信息
Immunogen sequence: MQRLLCCARR AARRRHATHG DRPRASGCLA RPGPPPSPGA ASDDDDDDVV GATPPARLLE PWAGCNGGAA ADSDSSLDEP CRPGFASESK V
靶标信息
Adrenergic receptors (ARs) are members of the 7-transmembrane domain G-protein-coupled receptor superfamily that bind the endogenous catecholamines epinephrine and norepinephrine. Pharmacological, structural, and molecular cloning data indicate significant heterogeneity within this receptor family. Nine receptor subtypes have been identified thus far including three alpha-1 AR subtypes (1A/D, 1B, and 1C), three alpha-2 ARs (2A, 2B, and 2C), and three beta AR subtypes (1, 2, and 3). ARs participate in either the onset or maintenance of several disease states including hypertension, cardiac dysfunction (congestive heart failure, ischemia, arrhythmias), diabetes, glaucoma, depression, and impotence. BARs participate in diverse processes including development, behavior, cardiac function, smooth muscle tone, and metabolism. In gene-knockout experiments, the majority of mice that lack the B1AR gene die prenatally and those that do survive until adulthood display abnormal cardiac function. Other studies have shown that the direct regulation of cardiac B1AR density by thyroid hormones occurs at the transcriptional level and is modulated by the catecholamine sensitive-adenylyl cyclase system. Evidence for the effects of cAMP on B1AR regulation has come from a study of members of the cAMP response element (CRE) modulator (CREM) family of transcription factors in transformed cell lines.
仅用于科研。不用于诊断过程。未经明确授权不得转售。
篇参考文献 (0)
生物信息学
蛋白别名: adrenergic receptor, beta 1; adrenergic, beta-1-, receptor; beta 1-adrenergic receptor beta 1-AR; beta 1-AR; Beta-1 adrenergic receptor; Beta-1 adrenoceptor; Beta-1 adrenoreceptor; beta-1-adrenergic receptor; cardiac beta adrenergic receptor
基因别名: Adrb-1; ADRB1; ADRB1R; B1AR; beta-AR; BETA1AR; FNSS2; RATB1AR; RHR
UniProt ID: (Human) P08588, (Mouse) P34971, (Rat) P18090
Entrez Gene ID: (Human) 153, (Mouse) 11554, (Rat) 24925